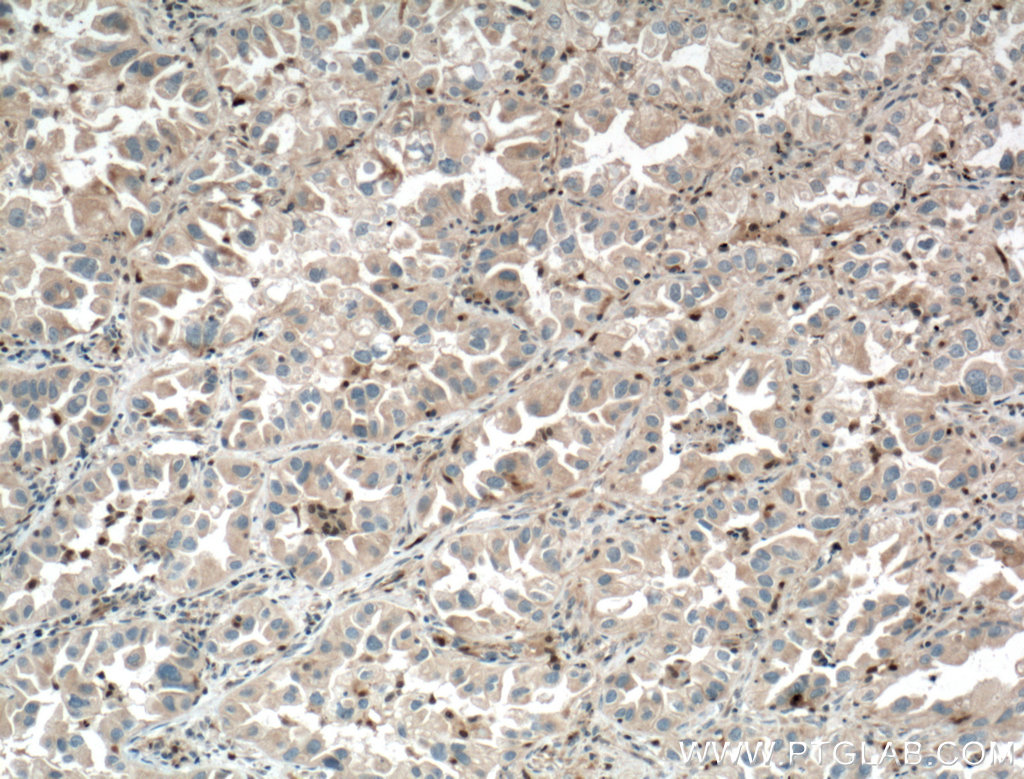

验证数据展示
经过测试的应用
| Positive WB detected in | mouse thymus tissue, HeLa cells, K-562 cells |
| Positive IHC detected in | human lung cancer tissue Note: suggested antigen retrieval with TE buffer pH 9.0; (*) Alternatively, antigen retrieval may be performed with citrate buffer pH 6.0 |
| Positive IF/ICC detected in | HepG2 cells |
推荐稀释比
| 应用 | 推荐稀释比 |
|---|---|
| Western Blot (WB) | WB : 1:500-1:1000 |
| Immunohistochemistry (IHC) | IHC : 1:50-1:500 |
| Immunofluorescence (IF)/ICC | IF/ICC : 1:10-1:100 |
| It is recommended that this reagent should be titrated in each testing system to obtain optimal results. | |
| Sample-dependent, Check data in validation data gallery. | |
产品信息
10362-1-AP targets Chk1 in WB, IF, IHC, ELISA applications and shows reactivity with human, mouse, rat samples.
| 经测试应用 | WB, IF, IHC, ELISA Application Description |
| 文献引用应用 | WB, IHC |
| 经测试反应性 | human, mouse, rat |
| 文献引用反应性 | human, mouse, rat |
| 免疫原 |
CatNo: Ag0409 Product name: Recombinant human CHK1 protein Source: e coli.-derived, PGEX-4T Tag: GST Domain: 42-256 aa of BC004202 Sequence: MKRAVDCPENIKKEICINKMLNHENVVKFYGHRREGNIQYLFLEYCSGGELFDRIEPDIGMPEPDAQRFFHQLMAGVVYLHGIGITHRDIKPENLLLDERDNLKISDFGLATVFRYNNRERLLNKMCGTLPYVAPELLKRREFHAEPVDVWSCGIVLTAMLAGELPWDQPSDSCQEYSDWKEKKTYLNPWKKIDSAPLALLHKILVENPSARITI 种属同源性预测 |
| 宿主/亚型 | Rabbit / IgG |
| 抗体类别 | Polyclonal |
| 产品类型 | Antibody |
| 全称 | CHK1 checkpoint homolog (S. pombe) |
| 别名 | CHEK1, Chk1 |
| 计算分子量 | 54 kDa |
| 观测分子量 | 50-55 kDa |
| GenBank蛋白编号 | BC004202 |
| 基因名称 | Chk1 |
| Gene ID (NCBI) | 1111 |
| 偶联类型 | Unconjugated |
| 形式 | Liquid |
| 纯化方式 | Antigen affinity purification |
| UNIPROT ID | O14757 |
| 储存缓冲液 | PBS with 0.02% sodium azide and 50% glycerol, pH 7.3. |
| 储存条件 | Store at -20°C. Stable for one year after shipment. Aliquoting is unnecessary for -20oC storage. |
背景介绍
In response to DNA damage, mammalian cells prevent cell cycle progression through the control of critical cell cycle regulators. CHK1 (synonym: CHEK1), a homolog of the Schizosaccharomyces pombe Chk1 protein kinase, is required for the DNA damage checkpoint. Human Chk1 protein is modified in response to DNA damage. In vitro Chk1 binds to and phosphorylate the dual-specificity protein phosphatases Cdc25A, Cdc25B, and Cdc25C, which control cell cycle transitions by dephosphorylating cyclin-dependent kinases. CHK1 can be autophosphorylated(PMID:22941630) and ubiquitinated (PMID:19276361). It has 3 isoforms produced by alternative splicing with the molecular weight of 54 kDa, 44 kDa and 50 kDa.
发表文章
| Species | Application | Title |
|---|---|---|
Nat Commun Human Tra2 proteins jointly control a CHEK1 splicing switch among alternative and constitutive target exons.
| ||
Proc Natl Acad Sci U S A Checkpoint kinase 1 (Chk1)-short is a splice variant and endogenous inhibitor of Chk1 that regulates cell cycle and DNA damage checkpoints. | ||
Oncotarget UBE2D3 gene overexpression increases radiosensitivity of EC109 esophageal cancer cells in vitro and in vivo. | ||
EBioMedicine High PARP-1 expression predicts poor survival in acute myeloid leukemia and PARP-1 inhibitor and SAHA-bendamustine hybrid inhibitor combination treatment synergistically enhances anti-tumor effects. | ||
Cell Death Dis HBV infection potentiates resistance to S-phase arrest-inducing chemotherapeutics by inhibiting CHK2 pathway in diffuse large B-cell lymphoma. | ||
Cell Death Dis PFKFB3 blockade inhibits hepatocellular carcinoma growth by impairing DNA repair through AKT. |